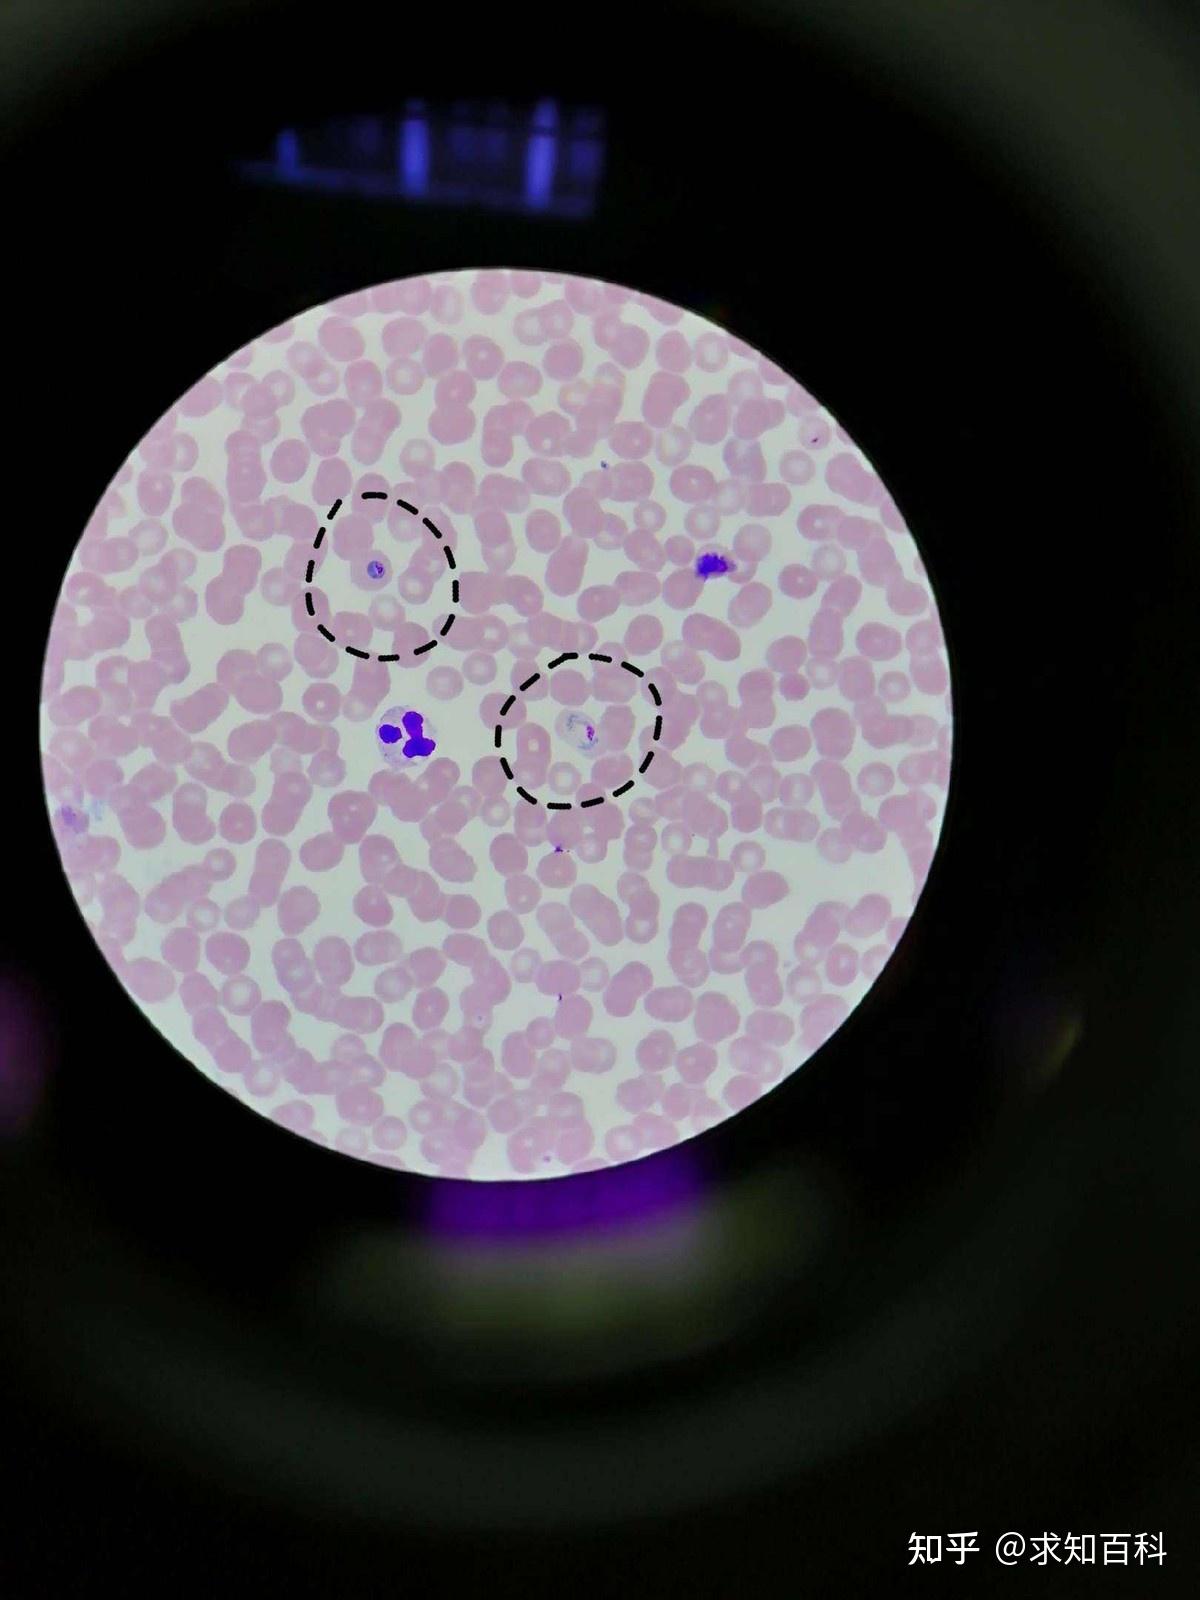
当捕猎者发现自己体内养着红藻,同时拥有了光合作用后,不用再辛苦地

红藻细胞

红藻细胞中贮藏1种非溶性碳水化合物,称红藻淀粉(floridean.starch).
图片尺寸302x280
【原生生物界全系列-05】原生生物界—红藻门|细胞|孢子|绿藻|植物体
图片尺寸640x480
雨生红球藻是一种主要生长在淡水中的单细胞绿藻,隶属绿藻门,团藻目
图片尺寸640x459
标本红藻摄影手法:不用屏障滤光片的反射照明/落射荧光(epi
图片尺寸590x425
红藻
图片尺寸214x143
该科多数是多细胞的,少数是单细胞的,该门只有红藻纲一纲,约有760属
图片尺寸808x602
首页
图片尺寸970x438
红藻图片简介大部分红藻是多细胞藻类研究显微镜出售
图片尺寸425x283
红藻门模式物种紫球藻细胞图
图片尺寸148x182
载色体
图片尺寸290x218
链藻:红藻门红藻纲,藻体具有一外倾的,匍匐的圆柱形或亚圆柱形,不规则
图片尺寸580x411
图片1.png
图片尺寸615x383
目前我们常食用的藻类中就有海胆,裙带菜和红藻门的紫菜等.
图片尺寸671x503
p>对丝藻的藻体纤细,丝状,丛生,由单列细胞组成,高0.5~1.
图片尺寸900x659
植物学54红藻门和褐藻门
图片尺寸920x690
比较常规,十二道高考试题涉及到生命的物质基础和结构基础,细胞代谢
图片尺寸600x450
当捕猎者发现自己体内养着红藻,同时拥有了光合作用后,不用再辛苦地
图片尺寸1200x1600
科学家发现最古老的植物:16亿年前的红藻
图片尺寸600x438
daniel knop#6 connections between brain cells大脑细胞之间的连接
图片尺寸700x432
实验室数据也显示加入红藻6小时后,表皮细胞代谢明显提升
图片尺寸1080x607